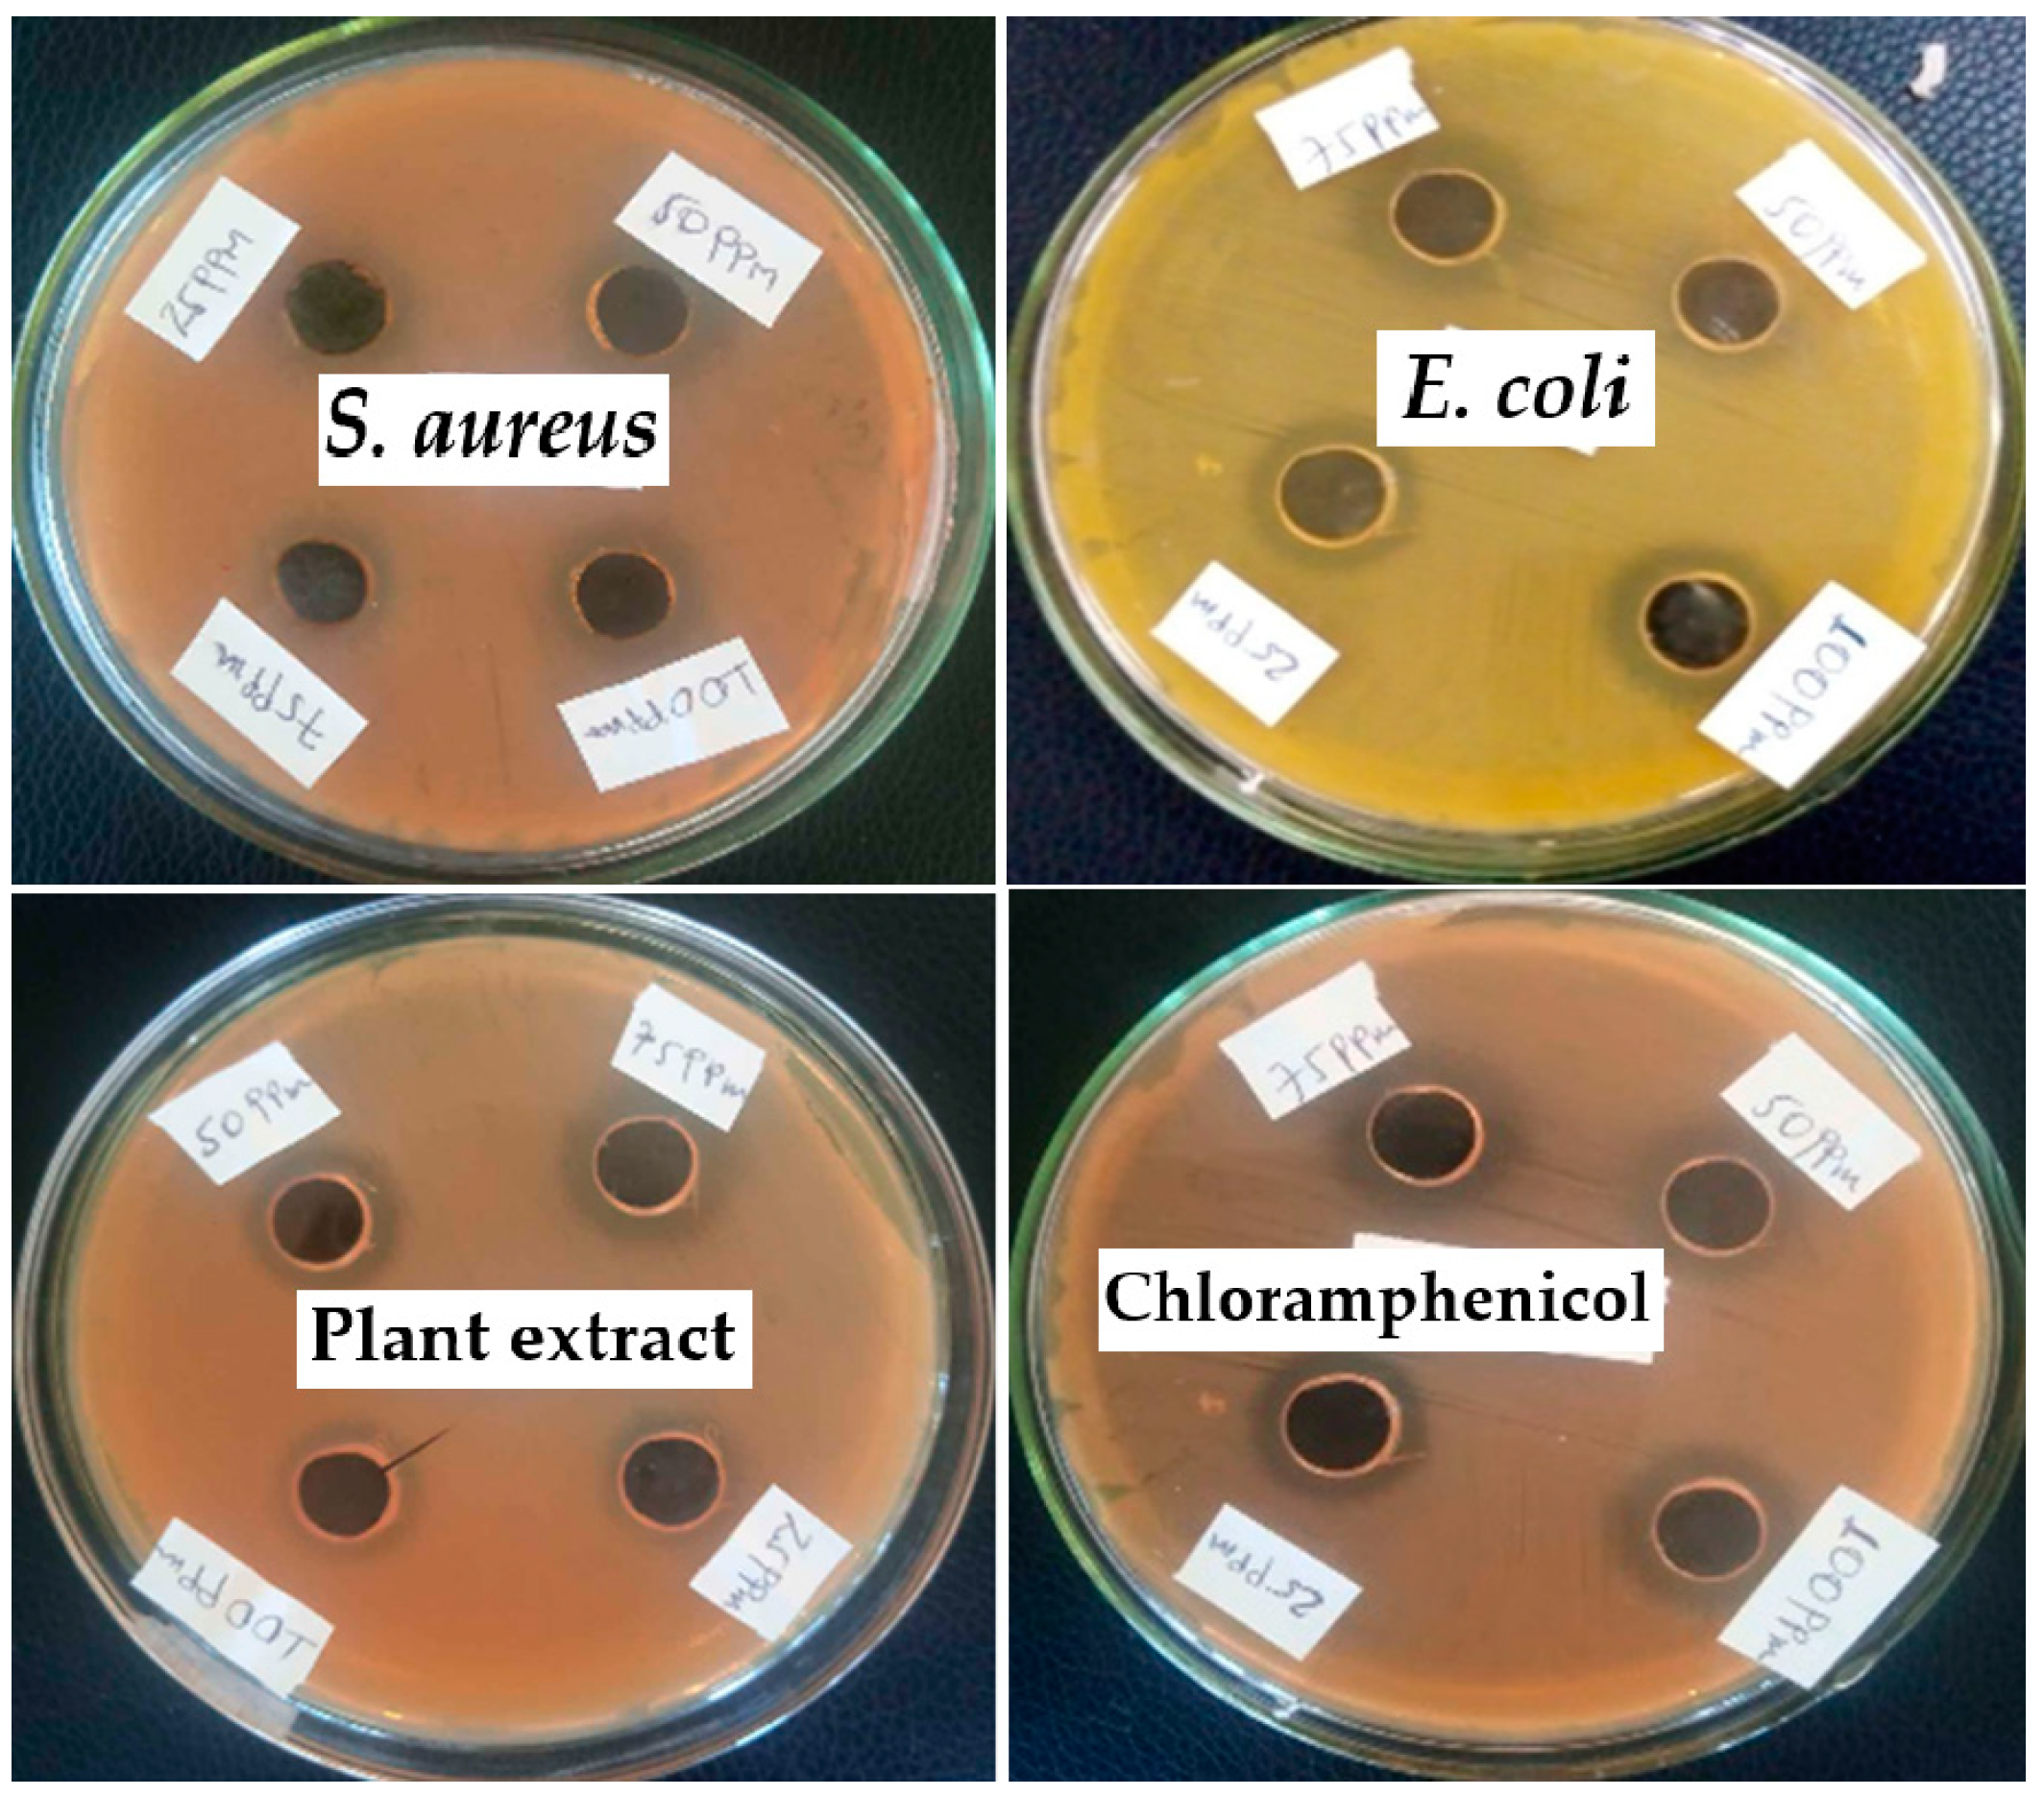
Materials 17 05835 g015 Materials 17 05835 g015

Green Synthesis of Titanium Dioxide Nanoparticles Using Maerua oblongifolia Root Bark Extract: Photocatalytic Degradation and Antibacterial Activities
Abstract
1. Introduction
2. Materials and Methods
2.1. Materials, Chemicals, and Instruments
2.2. Collection and Preparation of Plant Materials
2.3. Preparation of Root Bark Extracts
2.4. Isolations of M. oblongifolia Root Bark Saponin
2.5. Green Synthesis of TiO2 NPs
2.6. Characterization of Green-Synthesized TiO2 NPs
2.7. The Photocatalytic Degradation of Synthesized TiO2NPs
Optimization Parameters for Photocatalytic Degradations by BBD and RSM
2.8. Adsorption Isotherms and Kinetic Study
2.9. Recovery of Green-Synthesized Photocatalyst
2.10. Antibacterial Activities
2.10.1. Growth Media and Testing Microorganisms
2.10.2. Antibacterial Activity
3. Results and Discussion
3.1. Characterization of TiO2 NPs
3.2. Mechanism of Green Synthesis of TiO2 NPs by Using Plant Extracts
3.3. Surface Morphology
3.4. The Mechanism of the TiO2 NP Photocatalysis Process
3.5. Evaluations of Photocatalytic Degradation Efficiency
3.5.1. Effects of Sunlight Irradiation UV-Light (254 Nm) and Catalysts on Degradation
3.5.2. Optimization of the Degradation Process by the Model Equation
5.4AC − 3.6 AD +5.6 BC − 5.6BD + 11.48CD − 7.6A2 − 7.6B2 − 3.75C2 − 10.04D2
0.4AC − 2.15AD − 0.4BC − 4.4BD + 0.4CD − 0.2A2 − 0.49B2 + 1.28C2 + 5.6D2
3.5.3. ANOVA and Model Adequacy
3.5.4. Effects of Different Parameters on Photocatalytic Degradation Efficiency
- Effects of catalyst dosage and irradiation time
- b.
- Effects of pH and Catalytic Dos
- c.
- Effect of catalytic dose and initial dye concentration
3.6. Experimental Validation of the RSM Model
3.7. Adsorption Isotherm Models
3.8. Kinetics Study
3.9. Stability Studies
3.10. Recycling the Photocatalyst
3.11. Antibacterial Studies
4. Conclusions
Supplementary Materials
Author Contributions
Funding
Institutional Review Board Statement
Informed Consent Statement
Data Availability Statement
Acknowledgments
Conflicts of Interest
References
- Shindhal, T.; Rakholiya, P.; Varjani, S.; Pandey, A.; Ngo, H.; Taherzadeh, M. A critical review on advances in the practices and perspectives for the treatment of dye industry wastewater. Bioengineered 2021, 12, 7087. [Google Scholar] [CrossRef] [PubMed]
- Ajmal, A.; Majeed, I.; Malik, N.; Idriss, H.; Nadeem, M. Principles and mechanisms of photocatalytic dye degradation on TiO2 based Photocatalysts: A comparative overview. RSC Adv. 2014, 4, 37003–37026. [Google Scholar] [CrossRef]
- Mia, R.; Selim, M.; Shamim, A.; Chowdhury, M.; Sultana, S.; Armin, M.; Naznin, H. Review on various types of pollution problem in textile dyeing & printing industries of Bangladesh and recommendation for mitigation. J. Text. Eng. Fash. Technol. 2019, 5, 220–226. [Google Scholar]
- Gusain, R.; Gupta, K.; Joshi, P.; Khatri, O. Adsorptive removal and photocatalytic degradation of organic pollutants using metal oxides and their composites: A comprehensive review. Adv. Colloid Interface Sci. 2019, 272, 102009. [Google Scholar] [CrossRef] [PubMed]
- Gautam, S.; Kaithwas, G.; Bharagava, R.; Saxena, G. Pollutants in tannery wastewater: Pharmacological effects, and bioremediation approaches for human health protection and environmental safety. In Environmental Pollutants and Their Bioremediation Approaches; CRC Press: Boca Raton, FL, USA, 2017; Volume 1, pp. 369–396. [Google Scholar]
- Chausali, N.; Saxena, J.; Prasad, R. Nanotechnology as a sustainable approach for combating the environmental effects of climate change. J. Agric. Food Res. 2023, 12, 100541. [Google Scholar] [CrossRef]
- Chakhtouna, H.; Benzeid, H.; Zari, N.; Qaiss, A.; Bouhfid, R. Recent progress on Ag/TiO2 Photocatalysts: Photocatalytic and bactericidal behaviors. Environ. Sci. Pollut. Res. 2021, 28, 44638–44666. [Google Scholar] [CrossRef]
- Salam, A.; Sivaraj, R. Ocimum basilicum L. var. purpurascens Benth.-LAMIACEAE Mediated Green Synthesis and Characterization of zinc oxide Nanoparticles. Adv. Biores. 2014, 5, 122–126. [Google Scholar]
- Valli, G.; Geetha, S. A green method for the synthesis of TiO2 nanoparticles using Cassia auriculata leaves extract. Eur. J. Biomed. Pharm. Sci. 2014, 2, 490–497. [Google Scholar]
- Hudlikar, M.; Joglekar, S.; Dhaygude, M.; Kodam, K. Green synthesis of TiO2 nanoparticles by using aqueous extract of Jatropha curcas L. latex. Mater. Lett. 2012, 75, 196–199. [Google Scholar] [CrossRef]
- Ekero, D.; Legesse, M.; Lelago, A.; Agize, M. Extraction, Isolation and Characterization of Maerua oblongifolia (‘Sanagana’). Int. J. Curr. Res. Biosci. Plant Biol. 2018, 5, 42–48. [Google Scholar] [CrossRef][Green Version]
- Eseabara, C. Determination of Saponin Content of Various Parts of Six Citus Species. Int. Res. J. Pure Appl. Chem. 2014, 4, 137–143. [Google Scholar] [CrossRef]
- Sethy, N.; Arif, Z.; Mishra, P.; Kumar, P. Green synthesis of TiO2 nanoparticles from Syzygium cumini extract for photo-catalytic removal of lead (Pb) in explosive industrial wastewater. Green Process. Synth. 2020, 9, 171–181. [Google Scholar] [CrossRef]
- Ayoub, H.; Kassir, M.; Raad, M.; Bazzi, H.; Hijazi, A. Effect of Dye Structure on the Photodegradation Kinetic Using TiO2 Nanoparticles. J. Mater. Sci. Chem. Eng. 2017, 5, 31–45. [Google Scholar]
- Amini, M.; Ashrafi, M. Photocatalytic Degradation of Some Organic Dyes under Solar Light Irradiation Using TiO2 and ZnO Nanoparticles. Nano Chem. Res. 2017, 1, 79–86. [Google Scholar]
- Belachew, N.; Fekadu, R.; Ayalew Abebe, A. RSM-BBD optimization of Fenton-like degradation of 4-nitrophenol using magnetite impregnated kaolin. Air Soil Water Res. 2020, 13, 1178622120932124. [Google Scholar] [CrossRef]
- Arief, S.; Jamarun, N.; Stiadi, Y. Magnetically separable ZnO-MnFe2O4 nanocomposites synthesized in organic-free media for dye degradation under natural sunlight. Orient. J. Chem. 2017, 33, 2758. [Google Scholar]
- Jiang, Q.; Huang, J.; Ma, B.; Yang, Z.; Zhang, T.; Wang, X. Recyclable, Hierarchical Hollow Photocatalyst TiO2 and SiO2 Composite Microsphere Realized by Raspberry-Like SiO2. Colloids Surf. A Physicochem. Eng. Asp. 2020, 602, 125112. [Google Scholar] [CrossRef]
- Swathi, N.; Sandhiya, D.; Rajeshkumar, S.; Lakshmi, T. Green synthesis of TiO2 nanoparticles using Cassia fistula and its antibacterial activity. Int. J. Res. Pharm. Sci. 2019, 10, 856–860. [Google Scholar] [CrossRef]
- Aravind, M.; Amalanathan, M.; Mary, M. Synthesis of TiO2 nanoparticles by chemical and green synthesis methods and their multifaceted properties. SN Appl. Sci. 2021, 3, 1–10. [Google Scholar] [CrossRef]
- Devikala, S.; Abisharani, J.M.; Bharath, M. Biosynthesis of TiO2 nanoparticles from Caesalpinia pulcherrima flower extracts. Mater. Today Proc. 2021, 40, S185–S188. [Google Scholar] [CrossRef]
- Sunny, N.; Mathew, S.; Chandel, N.; Saravanan, P.; Rajeshkannan, R.; Rajasimman, M.; Vasseghian, Y.; Rajamohan, N.; Kumar, S. Green synthesis of titanium dioxide nanoparticles using plant biomass and their applications-A review. Chemosphere 2022, 300, 134612. [Google Scholar] [CrossRef] [PubMed]
- Thakur, K.; Kumar, A.; Kumar, D. Green synthesis of TiO2 nanoparticles using Azadirachta indica leaf extract and evaluation of their antibacterial activity. S. Afr. J. Bot. 2019, 124, 223–227. [Google Scholar] [CrossRef]
- Hasan, M.; Ullah, I.; Zulfiqar, H.; Naeem, K.; Iqbal, A.; Gul, H.; Ashfaq, M.; Mahmood, N. Biological entities as chemical reactors for the synthesis of nanomaterials: Progress, challenges and future perspective. Mater. Today Chem. 2018, 8, 13–28. [Google Scholar] [CrossRef]
- Sundrarajan, M.; Gowri, S. Green synthesis of silver and TiO2 nanoparticles by Nyctanthes arbor-tristis leaves extract. Chalcogenide Lett. 2011, 8, 447–451. [Google Scholar]
- Rajakumar, G.; Rahuman, A.; Priyamvada, B.; Khanna, G.; Kumar, K.; Sujin, P. Eclipta prostrata leaf aqueous extract mediated synthesis of TiO2 nanoparticles. Mater. Lett. 2012, 68, 115–117. [Google Scholar] [CrossRef]
- Roopan, M.; Bharathi, A.; Prabhakarn, A.; Rahuman, A.; Velayutham, K.; Rajakumar, G.; Madhumitha, G. Efficient phyto-synthesis and structural characterization of rutile TiO2 nanoparticles using Annona squamosa peel extract. Spectrochim. Acta Part A Mol. Biomol. Spectrosc. 2012, 1, 86–90. [Google Scholar] [CrossRef]
- Dodoo-Arhin, D.; Buabeng, F.; Mwabora, J.; Amaniampong, P.; Agbe, H.; Nyankson, E.; Obada, D.; Asiedu, N. The effect of titanium dioxide synthesis technique and its photocatalytic degradation of organic dye pollutants. Heliyon 2018, 4, e00681. [Google Scholar] [CrossRef]
- Liu, Z.; Jian, Z.; Fang, J.; Xu, X.; Zhu, X.; Wu, S. Low-temperature reverse microemulsion synthesis, characterization, and photocatalytic performance of nanocrystalline titanium dioxide. Int. J. Photoenergy 2012, 2012, 702503. [Google Scholar] [CrossRef]
- Bagheri, S.; Shameli, K.; Abd Hamid, S. Synthesis and characterization of anatase TiO2 nanoparticles using egg white solution via sol-gel method. J. Chem. 2013, 2013, 848205. [Google Scholar] [CrossRef]
- Sundrarajan, M.; Bama, K.; Bhavani, M.; Jegatheeswaran, S.; Ambika, S.; Sangili, A.; Sumathi, R. Obtaining TiO2 nanoparticles with spherical shape and antimicrobial properties using M. citrifolia leaves extract by hydrothermal method. J. Photochem. Photobiol. B Biol. 2017, 171, 117–124. [Google Scholar]
- Rehman, A.; Minhas, A. Green Route Synthesis of Copper Oxide Nanoparticles against MCF-7 Cell Line (Breast Cancer). NUST J. Nat. Sci. 2021, 6. [Google Scholar] [CrossRef]
- Goutam, S.P.; Saxena, G.; Singh, V.; Yadav, A.K.; Bharagava, R.N.; Thapa, K.B. Green synthesis of TiO2 nanoparticles using leaf extract of Jatropha curcas L. for photocatalytic degradation of tannery wastewater. Chem. Eng. J. 2018, 336, 386–396. [Google Scholar] [CrossRef]
- Nasrollahzadeh, M.; Sajadi, S.M. Synthesis and characterization of titanium dioxide nanoparticles using Euphorbia heteradena Jaub root extract and evaluation of their stability. Ceram. Int. 2015, 41, 14435–14439. [Google Scholar] [CrossRef]
- Ngoepe, M.; Mathipa, M.; Hintsho-Mbita, C. Biosynthesis of TiO2 nanoparticles for the photodegradation of dyes and removal of bacteria. Optik 2020, 224, 165728. [Google Scholar] [CrossRef]
- Sirota, V.; Selemenev, V.; Kovaleva, M.; Pavlenko, I.; Mamunin, K.; Dokalov, V.; Prozorova, M. Synthesis of Magnesium Oxide Nanopowder by Thermal Plasma Using Magnesium Nitrate Hexahydrate. Phys. Res. Int. 2016, 26, 234–238. [Google Scholar] [CrossRef]
- Reches, Y.; Thomson, K.; Helbing, M.; Kosson, S.; Sanchez, F. Agglomeration and reactivity of nanoparticles of SiO2, TiO2, Al2O3, Fe2O3, and clays in cement pastes and effects on compressive strength at ambient and elevated temperatures. Constr. Build. Mater. 2018, 167, 860–873. [Google Scholar] [CrossRef]
- Saini, R.; Kumar, P. Green synthesis of TiO2 nanoparticles using Tinospora cordifolia plant extract & its potential application for photocatalysis and antibacterial activity. Inorg. Chem. Commun. 2023, 156, 111221. [Google Scholar]
- Haneefa, M. Green Synthesis Characterization and Antimicrobial Activity Evaluation of Manganese Oxide Nanoparticles and Comparative Studies with Salicylal chitosan Functionalized Nanoform. Asian J. Pharm. 2017, 11, 65–74. [Google Scholar]
- Ahsan, H.; Shahid, M.; Imran, M.; Mahmood, F.; Hussain, S.; Shahbaz, M.; Ayyub, M.; Shahzad, T. Photocatalysis and adsorption kinetics of azo dyes by nanoparticles of nickel oxide and copper oxide and their nanocomposite in an aqueous medium. PeerJ 2022, 10, e14358. [Google Scholar] [CrossRef]
- Hassan, S.; El Azab, I.; Ali, R.; Mansour, M. Green synthesis and characterization of ZnO nanoparticles for photocatalytic degradation of anthracene. Adv. Nat. Sci. Nanosci. Nanotechnol. 2015, 6, 045012. [Google Scholar] [CrossRef]
- Oladipo, O.; Akinlabi, K.; Alayande, O.; Msagati, A.; Nyoni, H.; Ogunyinka, O. Synthesis, characterization, and photocatalytic activity of silver and zinc co-doped TiO2 nanoparticle for photodegradation of methyl orange dye in aqueous solution. Can. J. Chem. 2019, 97, 642–650. [Google Scholar] [CrossRef]
- Bhuiyan, H.; Miah, Y.; Paul, C.; Aka, D.; Saha, O.; Rahaman, M.M.; Ashaduzzaman, M. Green synthesis of iron oxide nanoparticle using Carica papaya leaf extract: Application for photocatalytic degradation of remazol yellow RR dye and antibacterial activity. Heliyon 2020, 6, e04603. [Google Scholar] [CrossRef] [PubMed]
- Rana, A.; Minceva, M. Analysis of Photocatalytic Degradation of Phenol with Exfoliated Graphitic Carbon Nitride and Light-Emitting Diodes Using Response Surface Methodology. Catalysts 2021, 11, 898–902. [Google Scholar] [CrossRef]
- Kweinor Tetteh, E.; Obotey Ezugbe, E.; Asante-Sackey, D.; Armah, K.; Rathilal, S. Response surface methodology: Photocatalytic degradation kinetics of basic blue 41 dye using activated carbon with TiO2. Molecules 2021, 26, 1068. [Google Scholar] [CrossRef] [PubMed]
- Iqbal, M.; Imran, M.; Hussain, T.; Naeem, A.; Al-Kahtani, A.; Shah, M.; Ali, S. Effective sequestration of Congo red dye with ZnO/cotton stalks biochar nanocomposite: MODELING, reusability and stability. J. Saudi Chem. Soc. 2021, 25, 101176. [Google Scholar] [CrossRef]
- Edet, A.; Ifelebuegu, A. Kinetics, isotherms, and thermodynamic modeling of the adsorption of phosphates from model wastewater using recycled brick waste. Processes 2020, 8, 665. [Google Scholar] [CrossRef]
- Kaur, H.; Kaur, S.; Singh, J.; Rawat, M.; Kumar, S. Expanding horizon: Green synthesis of TiO2 nanoparticles using Carica papaya leaves for photocatalysis application. Mater. Res. Express 2019, 6, 095034. [Google Scholar] [CrossRef]
- Chinnathambi, A.; Vasantharaj, S.; Saravanan, M.; Sathiyavimal, S.; Duc, P.A.; Nasif, O.; Alharbi, S.A.; Chi, N.T.L.; Brindhadevi, K. Biosynthesis of TiO2 nanoparticles by Acalypha indica; photocatalytic degradation of methylene blue. Appl. Nanosci. 2021, 13, 383–390. [Google Scholar] [CrossRef]
- Balaraman, P.; Balasubramanian, B.; Liu, W.C.; Kaliannan, D.; Durai, M.; Kamyab, H.; Alwetaishi, M.; Maluventhen, V.; Ashokkumar, V.; Chelliapan, S.; et al. Sargassum myriocystum-mediated TiO2-nanoparticles and their antimicrobial, larvicidal activities and enhanced photocatalytic degradation of various dyes. Environ. Res. 2022, 204, 112278. [Google Scholar] [CrossRef]
- Thandapani, K.; Kathiravan, M.; Namasivayam, E.; Padiksan, I.A.; Natesan, G.; Tiwari, M.; Giovanni, B.; Perumal, V. Enhanced larvicidal, antibacterial, and photocatalytic efficacy of TiO2 nanohybrids green synthesized using the aqueous leaf extract of Parthenium hysterophorus. Environ. Sci. Pollut. Res. 2018, 25, 10328–10339. [Google Scholar] [CrossRef]
- Shivaraju, H.; Midhun, G.; Kumar, K.; Pallavi, S.; Pallavi, N.; Behzad, N. Degradation of Selected Industrial Dyes Using Mg-Doped TiO2 Polyscales Under Natural Sun Light as an Alternative Driving Energy. Appl. Water Sci. 2017, 7, 3937–3948. [Google Scholar] [CrossRef]
- Alfei, S.; Schito, G.C.; Schito, A.M.; Zuccari, G. Reactive oxygen species (ROS)-Mediated antibacterial oxidative therapies: Available methods to generate ROS and a novel option proposal. Int. J. Mol. Sci. 2024, 25, 7182. [Google Scholar] [CrossRef] [PubMed]

| Independent Variables | Symbols | Ranges and Levels | ||
|---|---|---|---|---|
| Low | Middle | High | ||
| Irradiation time (minutes) | A | 15 | 127.5 | 240 |
| Catalyst dose (g) | B | 0.1 | 0.45 | 0.8 |
| Initial dye concentration (mg/L) | C | 20 | 110 | 200 |
| pH | D | 2 | 6 | 10 |
| Plant Used | Temperature | Particle Size (nm) | References |
|---|---|---|---|
| Jatropha curcas L. latex | 50 °C | 25 (XRD) | [10] |
| Nyctanthes arbor-tristis leaves | 50 °C | 100 (XRD) | [25] |
| Eclipta prostrata leaf | 25 °C | 49 (XRD) | [26] |
| Annona squamosal peel | 60 °C | 26 (XRD) | [27] |
| cassia auriculata leaves | - | 38 (XRD) | [9] |
| M. oblongifolia root bark before isolating saponin extract | - | 19.58 (XRD) | This study |
| M. oblongifolia root bark after isolating saponin extract | - | 24.61 (XRD) | This study |
| Orange peel | - | 19 (XRD) | [8] |
| Experimental Conditions | Degradation Efficiency (%) | |||||||
|---|---|---|---|---|---|---|---|---|
| MB | MO | |||||||
| Run | A | B | C | D | Expt. | Predicted | Expt. | Predicted |
| 1 | 127.5 | 0.45 | 200 | 10 | 97 | 97.31 | 74.96 | 75.15 |
| 2 | 127.5 | 0.1 | 110 | 10 | 91 | 90.91 | 78 | 78.24 |
| 3 | 240 | 0.1 | 110 | 6 | 94.2 | 94.59 | 73.12 | 73.02 |
| 4 | 15 | 0.45 | 200 | 6 | 81.77 | 83.01 | 74.3 | 74.23 |
| 5 | 127.5 | 0.45 | 110 | 6 | 95.85 | 95.37 | 75.65 | 75.3 |
| 6 | 127.5 | 0.1 | 20 | 6 | 92 | 92.96 | 77.2 | 76.88 |
| 7 | 15 | 0.45 | 110 | 10 | 76 | 75.07 | 78.07 | 78.67 |
| 8 | 240 | 0.8 | 110 | 6 | 83 | 82.5 | 76.6 | 76.34 |
| 9 | 15 | 0.8 | 110 | 6 | 67.33 | 66.85 | 77.12 | 76.69 |
| 10 | 127.5 | 0.45 | 110 | 6 | 95 | 95.37 | 75.9 | 75.61 |
| 11 | 15 | 0.1 | 110 | 6 | 76.02 | 76.43 | 73.42 | 73.47 |
| 12 | 15 | 0.45 | 110 | 2 | 64.2 | 63.41 | 83.88 | 84.16 |
| 13 | 240 | 0.45 | 110 | 2 | 86.4 | 87.56 | 88.2 | 87.96 |
| 14 | 240 | 0.45 | 20 | 6 | 97.23 | 95.82 | 78 | 78.67 |
| 15 | 127.5 | 0.45 | 200 | 2 | 69.12 | 69.93 | 84.6 | 84.52 |
| 16 | 127.5 | 0.45 | 20 | 2 | 89.2 | 88.80 | 91 | 90.56 |
| 17 | 15 | 0.45 | 20 | 6 | 67.54 | 68.06 | 79.9 | 79.97 |
| 18 | 127.5 | 0.45 | 110 | 6 | 95.5 | 95.37 | 75.9 | 75.61 |
| 19 | 127.5 | 0.8 | 110 | 2 | 75.75 | 75.67 | 91.8 | 91.86 |
| 20 | 127.5 | 0.45 | 110 | 6 | 94.5 | 95.37 | 75.31 | 75.61 |
| 21 | 127.5 | 0.8 | 200 | 6 | 86.95 | 86.22 | 74.79 | 75.06 |
| 22 | 127.5 | 0.8 | 20 | 6 | 69.7 | 70.90 | 81 | 81.18 |
| 23 | 127.5 | 0.8 | 110 | 10 | 68.3 | 68.86 | 73.01 | 72.92 |
| 24 | 240 | 0.45 | 200 | 6 | 89.73 | 89.05 | 74 | 74.25 |
| 25 | 127.5 | 0.45 | 110 | 6 | 96 | 95.37 | 75.3 | 75.61 |
| 26 | 127.5 | 0.45 | 20 | 10 | 71.16 | 70.26 | 79.77 | 79.57 |
| 27 | 127.5 | 0.1 | 200 | 6 | 86.8 | 85.82 | 72.73 | 72.51 |
| 28 | 240 | 0.45 | 110 | 10 | 83.7 | 84.72 | 73.8 | 73.47 |
| 29 | 127.5 | 0.1 | 110 | 2 | 76.02 | 75.29 | 79.3 | 79.42 |
| Dyes | Std.Dev. | Mean | C.V.% | R2 | Adjusted R2 | Predicted R2 | Adeq Precision |
|---|---|---|---|---|---|---|---|
| MB | 1.10 | 83.34 | 1.32 | 0.9949 | 0.9898 | 0.9726 | 42.8642 |
| MO | 0.3905 | 78.16 | 0.4996 | 0.9972 | 0.9943 | 0.9857 | 68.9120 |
| Isotherm Model | Parameters | MB | MO |
|---|---|---|---|
| Langmuir | qmax (mg/g) | 142.85 | 0.465 |
| RL | 0.0412 | 0.00029 | |
| R2 | 0.996 | 0.979 | |
| Freundlich | 1/n | 0.99047 | 1.266 |
| Kf (mg/g) | 0.985 | 1.2835 | |
| R2 | 0.993 | 0.962 | |
| Timken | KT (L/mg) | 0.078 | 17.35 |
| BT (J/mol) | 29.65 | 16.72 | |
| R2 | 0.981 | 0.95 |
| Plant Species | Light Sources | Dye | Concertation | Time (min) | Dose | Degradation (%) | References |
|---|---|---|---|---|---|---|---|
| Jatropha curcas | Sunlight | CV | 7 ppm | 300 | 500 mg | 76 | [10] |
| Carica papaya leaves | UV | RO | 4 ppm | 180 | 25 mg | 91 | [48] |
| A. indica | Sunlight | MB | 10 ppm | 360 | 50 mg | 99 | [49] |
| Sargassum myriocystum | Sunlight | MB | - | 45 | - | 93 | [50] |
| Monsonia Burkeana | UV, 150W | MB | 20 ppm | 120 | 60 | 85% | [35] |
| Parthernium hysterophorus | UV | MO | 1 ppm | 360 | 10 mg | 82 | [51] |
| M. oblongifolia | Sunlight | MB | 200 ppm | 127.5 | 0.45 g | 97 | This study |
| M. oblongifolia | Sunlight | MO | 110 ppm | 127.5 | 0.45 g | 91 | This study |
| Concentration | TiO2 NPs * | TiO2 NPs ** | Chloramphenicol | |||
|---|---|---|---|---|---|---|
| E. coli | S. aureus | E. coli | S. aureus | E. coli | S. aureus | |
| 25 ppm | 12 ± 0.34 | 9 ± 0.2 | 7 ± 0.28 | 5 ± 0.33 | 8 ± 0.12 | 10 ± 0.51 |
| 50 ppm | 18 ± 0.21 | 14 ± 0.46 | 11 ± 0.36 | 8 ± 0.37 | 13 ± 0.2 | 12 ± 0.38 |
| 75 ppm | 21 ± 0.47 | 16 ± 0.45 | 15 ± 0.48 | 12 ± 0.68 | 19 ± 0.53 | 14 ± 0.42 |
| 100 ppm | 27 ± 0.52 | 22 ± 0.61 | 18 ± 0.38 | 13 ± 0.18 | 25 ± 0.4 | 20 ± 0.43 |
Disclaimer/Publisher’s Note: The statements, opinions and data contained in all publications are solely those of the individual author(s) and contributor(s) and not of MDPI and/or the editor(s). MDPI and/or the editor(s) disclaim responsibility for any injury to people or property resulting from any ideas, methods, instructions or products referred to in the content. |
© 2024 by the authors. Licensee MDPI, Basel, Switzerland. This article is an open access article distributed under the terms and conditions of the Creative Commons Attribution (CC BY) license (https://creativecommons.org/licenses/by/4.0/).
Share and Cite
Dilika, M.D.; Fanta, G.M.; Tański, T. Green Synthesis of Titanium Dioxide Nanoparticles Using Maerua oblongifolia Root Bark Extract: Photocatalytic Degradation and Antibacterial Activities. Materials 2024, 17, 5835. https://doi.org/10.3390/ma17235835
Dilika MD, Fanta GM, Tański T. Green Synthesis of Titanium Dioxide Nanoparticles Using Maerua oblongifolia Root Bark Extract: Photocatalytic Degradation and Antibacterial Activities. Materials. 2024; 17(23):5835. https://doi.org/10.3390/ma17235835
Chicago/Turabian StyleDilika, Mamo Dikamu, Gada Muleta Fanta, and Tomasz Tański. 2024. "Green Synthesis of Titanium Dioxide Nanoparticles Using Maerua oblongifolia Root Bark Extract: Photocatalytic Degradation and Antibacterial Activities" Materials 17, no. 23: 5835. https://doi.org/10.3390/ma17235835
APA StyleDilika, M. D., Fanta, G. M., & Tański, T. (2024). Green Synthesis of Titanium Dioxide Nanoparticles Using Maerua oblongifolia Root Bark Extract: Photocatalytic Degradation and Antibacterial Activities. Materials, 17(23), 5835. https://doi.org/10.3390/ma17235835

